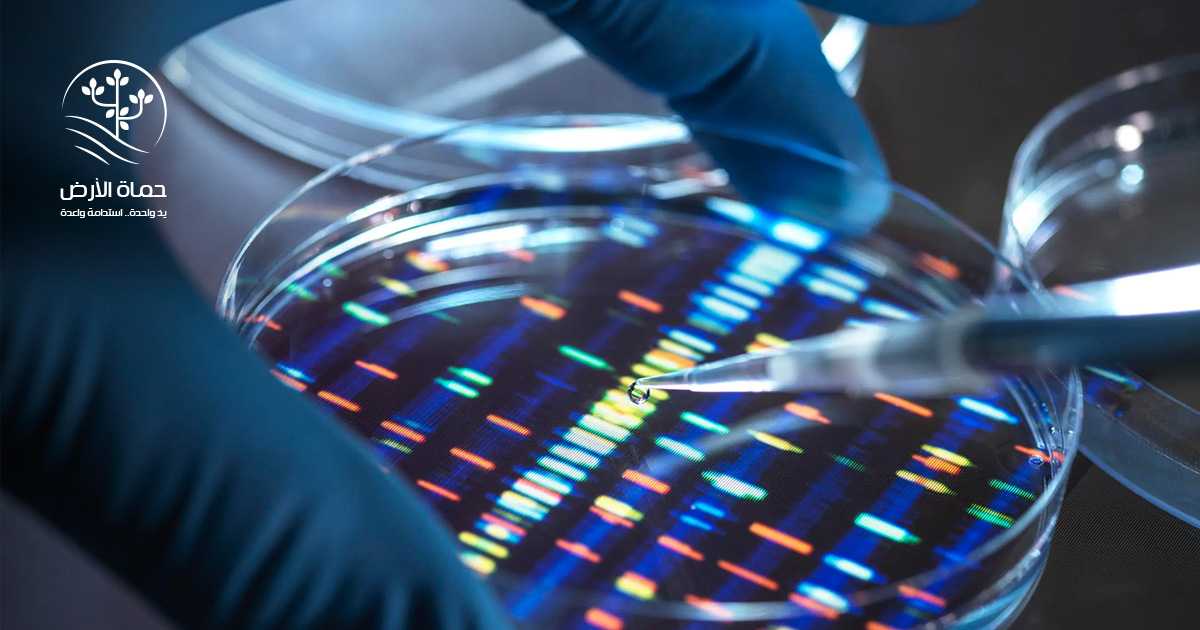
الجينوم

إنجاز علمي.. الجينوم البشري في أول تحليل كامل بأياد مصرية
إنجاز علمي.. الجينوم البشري في أول تحليل كامل بأياد مصرية
أصبحت العلاقة بين العلم والتنمية أكثر تداخلًا في السنوات الأخيرة، لا سيّما مع التقدّم المتسارع في تقنيات الجينوم والذكاء الاصطناعي؛ إذ لم تعد أبحاث الهندسة الوراثية مقصرةً على مجالات الطب الحيوي فحسب؛ لأنها امتدت إلى مجالات أخرى كالتخطيط الديموجرافي والرياضة والتعليم.
وفي هذا السياق العالمي المتغير أصبحت الدول في حاجةٍ إلى امتلاك خرائط جينية خاصة بها، ليكون هذا أساسَ استقلالها المعرفي، ومصدر إنتاجها الوطني، واليوم استطاعت مصر أنْ تكون واحدة من الدول التي تسعى إلى ذلك من خلال إنجاز علمي، وهو ما تكشف عنه حماة الأرض في السطور القادمة؛ فتابعوا القراءة.
حضارة وتاريخ
إنَّ مصر بتاريخها الممتد في الطب القديم، وبموقعها الجيوسياسي وديموجرافيتها المتنوعة، تُعد من أكثر الدول احتياجًا وأهليةً لأنْ تمتلك مشروعًا جينوميًّا وطنيًّا. وهو ما بدأت ملامحه تتبلور من خلال جهود علمية حثيثة، تقودها مؤسسات بحثية ذات كفاءة سيادية ومدنية. وما إنجاز “الجينوم المرجعي للمصريين وقدماء المصريين” إلا خطوة نوعية في هذا الاتجاه، وهي خطوة تعكس وعيًا متناميًا بأهمية العلم في بناء الإنسان، وحماية الأمن القومي، وتحقيق أهداف التنمية المستدامة.
ففي إنجاز علمي غير مسبوق على مستوى مصر، أعلن مركز البحوث الطبية والطب التجديدي التابع للقوات المسلحة عن نشر أول دراسة بحثية مصرية كاملة في مجال الجينوم البشري، تناولت أحد الأمراض النادرة التي تصيب الكُلى بالفشل الكلوي.
وقد نُشرت هذه الدراسة في واحدة من أرفع الدوريات العالمية المتخصصة في علم الجينات البشرية، والصادرة عن دار النشر الشهيرة “سبرينجر”؛ مما يؤكد الاعتراف الدولي بجودة البحث المصري وريادته في هذا المجال الحيوي.
وهو حدث يُمثّل تحوُّلًا عميقًا في طريقة تعامل مصر مع البحث العلمي، لا سيّما في المجالات الطبية المتقدمة؛ فلأول مرَّة يُنجز فريق مصري بالكامل هذا المستوى من البحث المتقدم داخل البلاد، باستخدام أحدث ما توصلت إليه التكنولوجيا الحيوية والذكاء الاصطناعي.
وتم تنفيذ هذه الدراسة بالتعاون بين مركز البحوث الطبية والطب التجديدي وجامعة القاهرة، وهو ما يعكس أهمية الشراكات المحلية بين المؤسسات السيادية والجامعات الوطنية؛ مُبرِزَةً قدرة مصر على تقديم حلول طبية مُوجَّهة خصوصًا إلى احتياجات سكانها، وذلك بالاستناد إلى الخصائص الجينية للمجتمع المصري، بدلًا من الاعتماد على نماذج مستوردة لا تراعي الفروقات الوراثية بين الشعوب.
مشروع وطني
يأتي هذا الإنجاز العلمي في سياق مشروع وطني طموح يُعرف باسم “الجينوم المرجعي للمصريين وقدماء المصريين”، الذي يهدف إلى بناء قاعدة بيانات جينية شاملة تسهم في تحسين أساليب التشخيص والعلاج، وتُمهّد الطريق لتطوير الطب الدقيق والموجَّه، من خلال ربط الطب بالتقنيات الجينية والذكاء الاصطناعي.
ويمتلك مركز البحوث الطبية والطب التجديدي واحدًا من أكثر المعامل تطورًا في مصر وإفريقيا، وهو معمل الجينوم الحديث، المُجهّز بأحدث الأجهزة والتقنيات العالمية. ويضم المركز أيضًا أكبر بنك حيوي أوتوماتيكي في القارة كلها؛ أي أنه في موقع تنافسي متقدم مقارنةً بالمراكز العالمية المماثلة.
ولا تقتصر البنية التحتية المتطورة على المباني أو التجهيزات فحسب، بل تعكس رؤية استراتيجية واضحة تهدف إلى تمكين الباحثين المصريين من أداء مهامهم بكفاءة عالمية. وقد تجلّى هذا التمكين في تنامي عدد الأبحاث المنشورة مؤخرًا في دوريات علمية مرموقة؛ الأمر الذي يمكنه أنْ يفتح الباب أمام آفاق جديدة للباحثين في مجالات الطب الجيني والتشخيص المتقدم.

والأهم من ذلك هو أنَّ هذه المنظومة البحثية بدأت تؤتي ثمارها فعليًّا، ليس فقط في مجال النشر الأكاديمي، بل أيضًا على صعيد التطبيق العملي؛ إذْ تُسهم نتائج الأبحاث الجينية في تطوير بروتوكولات علاجية مخصصة تتلاءم مع التركيبة الجينية للمصريين؛ ما يحد من الأخطاء الطبية، ويُحسِّن فاعلية العلاج.
الجينوم بين الطب والرياضة
لم تتوقف طموحات مركز البحوث الطبية عند حدود الأمراض والتشخيص الطبي، بل امتدت إلى مجالات جديدة مثل الطب الرياضي، من خلال مشروع “الجينوم الرياضي”. وقد أعلن المركز مؤخرًا عن نتائج هذا المشروع خلال المؤتمر العلمي الأول تحت عنوان ” CODE YOUR SPORTS POTENTIAL ” الذي شهد أيضًا إطلاق المرحلة الجديدة من اختبار الجين الرياضي”NEXT-GENE” ، المُصمَّم لتحليل الصفات الوراثية المرتبطة بالأداء الرياضي.
ويمثل هذا المشروع -أيضًا- نقلةً نوعيةً في آليات اكتشاف المواهب الرياضية؛ إذ لم يعد تقييم الأداء الرياضي قائمًا على المؤشرات الظاهرة فقط، بل أصبح للبعد الجيني دور في توجيه الرياضيين نحو التخصصات المناسبة لقدراتهم الوراثية. هذا التوجّه العلمي يقلل من الهدر في الوقت والموارد، ويعزّز دقة الاختيارات؛ مما يفتح آفاقًا غير مسبوقة لتطوير الرياضة الوطنية بالاستناد إلى علم الجينات.
كما أنَّ تكامل البحث الجيني مع الرياضة يعكس رؤية وطنية شاملة لتطوير أداء الإنسان المصري في كل المجالات، وهو ما يتوافق مع التوجهات الوطنية نحو تمكين الشباب وتطوير قدراتهم التنافسية.
رؤية استراتيجية للتنمية البشرية
وبناءً على ما سبق أكد مدير المركز خلال كلمته في المؤتمر أنَّ هذه المشروعات العلمية لا تنفصل عن رؤية الدولة في تحقيق التنمية البشرية المستدامة، مشيرًا إلى أن معرفة الجينات البشرية تُعد مدخلًا محوريًّا لفهم طبيعة الإنسان المصري واحتياجاته الصحية والنفسية والرياضية.
وتتجاوز هذه الرؤية المفهوم التقليدي للبحث العلمي بوصفه نشاطًا نظريًّا، لتجعله أداة حيوية في رسم السياسات الصحية والتعليمية والرياضية، استنادًا إلى بيانات دقيقة ومحددة؛ ومِن ثَمَّ فإنَّ هذا النهج العلمي يسهم في استغلال الموارد البشرية بأقصى كفاءة، ويقلل من هدر الكفاءات والجهود.
كما أنَّ الاعتماد على القدرات المحلية في تنفيذ هذه المشروعات يعزز الاستقلالية، ويُقلّل من التبعية للخارج، ويجعل من العلم عنصرًا أساسيًّا في استراتيجية الأمن القومي والتنمية الشاملة، بل يكرِّس هذا ثقةَ الدولة في كوادرها، ويُثبت أنَّ مصر قادرة على تحقيق إنجازات نوعية متى توافرت الإرادة والبيئة المناسبة.
نحو بناء مستقبل مستدام
في نهاية المطاف فإنَّ ما يقوم به مركز البحوث الطبية والطب التجديدي هو أكثر من مجرد بحث علمي، إنه مشروع لبناء مستقبل مستدام يربط بين المعرفة والهوية الوطنية، ويُجسِّد رؤية تنموية تتكامل فيها الصحة والتعليم والابتكار.
وهذه الرؤية تنسجم بوضوح مع أهداف التنمية المستدامة، لا سيما الهدف الثالث (الصحة الجيدة والرفاه)، والهدف التاسع (الصناعة والابتكار والهياكل الأساسية)، وهذا يعزز من موقع مصر باعتبارها دولة فاعلة في رسم ملامح المستقبل العلمي للمنطقة.
في الختام، ترى حماة الأرض أنَّ العلم حين يُسْنَدُ بإرادة سياسية قوية، ودعم مؤسسي واعٍ؛ يمكن أنْ يتحول إلى قوة تغيير حقيقية، وهو الأمر الذي يحققه مشروع الجينوم المصري، الذي يجعل من التنمية المستدامة ضرورةً لبناء أمة متقدمة، وعادلة، وقادرة على صناعة مستقبلها بيد أبنائها.






